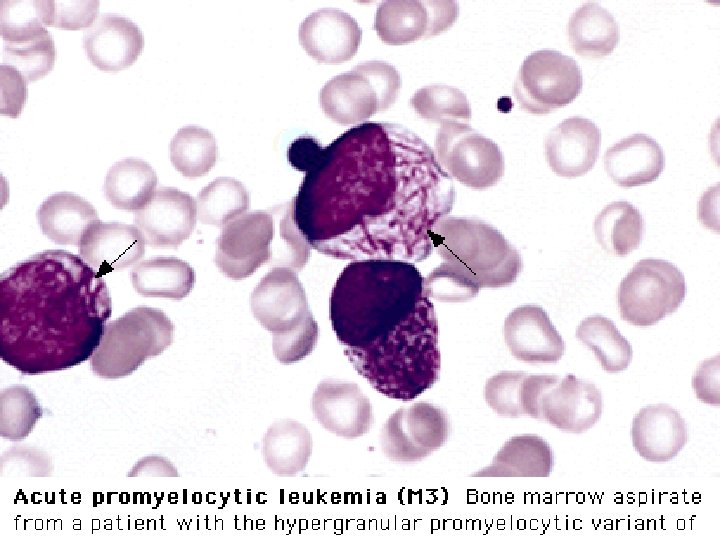

The acute Leukemias are clonal hematopoietic malignant disease

- Slides: 44
The acute Leukemias are clonal hematopoietic malignant disease that arise from the malignant Transformation of an early Hematopoietic stem cell. Dr. Azarm
Known risk factors for leukemia High dose radiation exposure Occupational exposure to benzene Prior chemotherapy especially alkylating agents Chromosomal instability disorders, such as - Bloom’s syndrome, - Fanconi’s anemia, - Downs syndrome, - Ataxia telangiectasia. Dr. Azarm
Acute leukemiais are classified by cell linesge into (1) acute myelogenous leukemia (AML) or (2) acute lymphoblastic leukemia (ALL) based on: - Morphology - Cytogenetics - Cell surface -Cytoplasmic markers -Molecular studies Dr. Azarm
Complication of Leukemia -Bone Marrow failure Anemia , Leukopenia, Thrombocytopenia -Infection -Bleeding -Blast infiltration in: Bone Marrow Pripheral Blood Lymph nodes spleen Liver Skin Meningeal Other Organs
FAB Classification of acute Leukemia Acute Myeloblastic Leukemia M 1 - Acute Myeloblastic L. without differentiation M 2 - A. M. L. with diferentiation (predominantly Myloblast & promyeloblast M 3 - Acute promyeloblatic leukemia M 4 - Acute Myelomonocytic leukemia M 5 - Acute Monocytic Leukemia M 6 - Erythroleukemia M 7 - Megakariocytic Leukemia Acute Lymphoblastic Leukemia L 1 - Small cells, Homogeneous population, childhood variant. L 2 - Larger L. Heterogeneous population, adult variant L 3 - Burkitt-like Large cells , Vacuolated cytoplasm
Cytogenetics in AML t(15; 17) in M 3 t(8; 21) in M 2 Inv(16) in M 4 Eo, are associated with better prognosis. Monosomy 7 and multiple breakages , ( poor prognosis ).
Investigation and diagnosis FBC and PB film Bone marrow aspiration and biopsy High WBC with Blast , but may be low. Platelet & Hb usually low Marrow with Blast infiltrated >30% Immunophenotyping and Karyotyping allows classification
Supportive treatment - Give explanation and offer counselling - RBC and platelet transfusion - Start hydration and Allopurinol Po - Insert tunnelled central venous ccatheter - Start neutropenic regimen and prophylaxis
Specific treatment in AML - Treatment protocols are age related; patients. 60 y only tolerate less intensive treat and very rarely transplant Supportive treatment alone is a valid treatment option in the >75 age group Outline treatment for patients <60 y is 4 - 5 courses of intensive combination chemotherapy each 5 -10 days with 2 - 3 w. Allogeneic or autologous stem cell transplantation are option for younger patients Major complication are infection , Bacterial , Fungal, In the longer term , relapse is the main complication. Viral.
Prognosis of AML Worst prognosis group: <10% chance cure: - Age >60 y - High WBC - >20% blast after chemotherapy course 1 - CNS disease Good prognosis group : > 60% chance cure: - Young patients<30 - T(15; 17) - M 3 subtype
Treatment plan for ALL 2 phase induction chemotherapy to induce remission 2 or 4 intensification + intrathecal methotrexate or CNS radiation Maintenance therapy for 2 y (out patient oral chemotherapy) Transplant options: - Allogeneic and autologous for child who relapse after CR. Adult in first CR < 60 y especially if philadelphia positive.
Prognosis of ALL Childhood ALL has a cure rate of > 70% up to 90% in the best prognostic group ie girls Aged 1 - 10 y with low WBC , no CNS disease and absence of Ph chromosome who achieve CR after first phase induction chemotherapy.